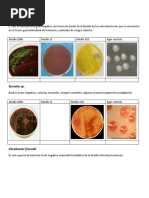

0% encontró este documento útil (0 votos)
202 vistas7 páginasEstructura y Funciones de Células Procariotas
Las células procariotas son las más simples y pequeñas. No tienen núcleo ni organelas, y su ADN circular se encuentra libre en el citoplasma. Se caracterizan por poseer una pared celular rígida compuesta generalmente de peptidoglicano, y una membrana con pliegues llamados mesosomas donde se lleva a cabo la respiración. Las bacterias son procariotas que se reproducen por fisión binaria y pueden intercambiar material genético a través de estructuras como los fimbrias.
Cargado por
HECTOR AVENDAÑO RAMOSDerechos de autor
© © All Rights Reserved
Nos tomamos en serio los derechos de los contenidos. Si sospechas que se trata de tu contenido, reclámalo aquí.
Formatos disponibles
Descarga como DOC, PDF, TXT o lee en línea desde Scribd
0% encontró este documento útil (0 votos)
202 vistas7 páginasEstructura y Funciones de Células Procariotas
Las células procariotas son las más simples y pequeñas. No tienen núcleo ni organelas, y su ADN circular se encuentra libre en el citoplasma. Se caracterizan por poseer una pared celular rígida compuesta generalmente de peptidoglicano, y una membrana con pliegues llamados mesosomas donde se lleva a cabo la respiración. Las bacterias son procariotas que se reproducen por fisión binaria y pueden intercambiar material genético a través de estructuras como los fimbrias.
Cargado por
HECTOR AVENDAÑO RAMOSDerechos de autor
© © All Rights Reserved
Nos tomamos en serio los derechos de los contenidos. Si sospechas que se trata de tu contenido, reclámalo aquí.
Formatos disponibles
Descarga como DOC, PDF, TXT o lee en línea desde Scribd